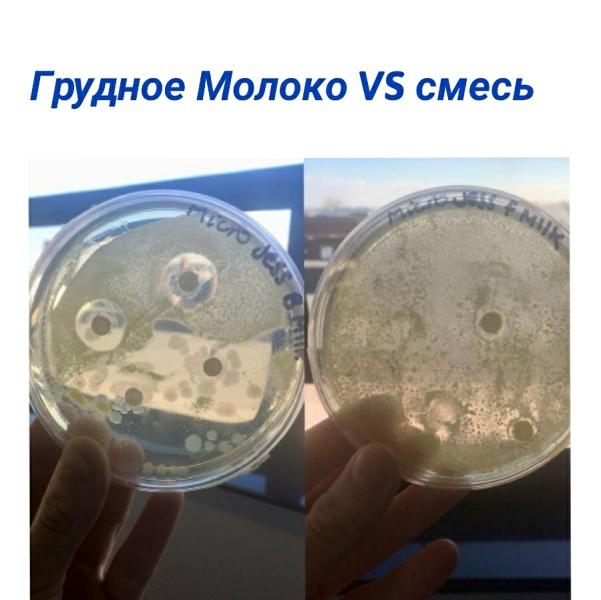
post image

Мамочки, вот как быть?😳
У нас завтра вылет в Египет, мы этот отпуск 3 года ждали, пахали как лошади без выходных. И вчера у малого поднялась температура до 39😔Ни соплей, ни кашля, сам бодрый. Нурофен сбивает, утром 37.
Понимаю, что так лететь нельзя😩Что делать то?😭
Берите его лучше с собой, там морским воздухом надышиттся, и лекарства в египте говорят хорошие!!!
@vikakimushka, есть, но я тогда не отдохну😔буду о нем переживать не меньше на расстоянии😩
@kurulova2, еще нет, завтра вылет. Наблюдаем и думаем как лучше поступить. Врач сказала что можно лететь, но риски есть
У нас перед вылетом в Тай заболел Дамир, показали врачу, взяли с собой абсолютно все лекарства чем я пользовалась в прошлые разы, взяли с собой антибиотик на всякий случай
Воно так завжди😕наче навмистно😪подивіться якщо не червоне горло,то це на зуби,або сходіть до лікаря щоб остаточно убідитись що це не вірус.Але якщо це на зуби то імунітет понизився,то якщо іхати відпочивати,яб радила вам дати щось проти вірусу.
Я думаю зубы , у нас было точно также ! Сбивала нурофеном. Правда два дня продержалась.
@singaeva @marusikanna0 девчата, анализы информативны на третий день болезни. Если сдать сейчас, могут ничегошеньки не показать.
Похоже на вирус, переболели таким пару недель назад. Из симптомов - только температура.
Ничем не лечили, только сбивали темпу. Покажите обязательно врачу, пусть посмотрит горло,нос,уши, послушает легкие. А лететь, к сожалению, нельзя. По крайней мере, ребенку.
Как часто поднимается?пить больше давайте!сдали б утром кровь??а потом в интернете посмотрели результат и отправите врачу если боитесь ???
У нас на зубы такое было три дня,без соплей и прочего.Черещ три дня все прошло,а на четвёртый вылез зуб...По поводу поездки не знаю,даже...🤔
Всем привет ☺️
Неделю назад получила результат анализа пола. Вся семья (муж, родители) скрещивала все что можно на мальчишку 👶🏻 Замечала, как они считали минутки до результата, ждали с трепетом в голосе... и очень переживали 🙈 Так им хотелось сына и внука🙏🏼☺️ (видно после двух внучек-близняшек😂). А я просто тихо ждала результатов, ведь для меня если честно это оказалось не столь важным (главное, здоровенький, как говорится 🙏🏼)
Не знаю, то ли сверху их услышали, то просто совпадение 🤷🏻♀️😅 но результат МА...
Потрясающий эксперимент Jessica Wilson! Были взяты две чашки Петри с бактериями micrococcus luteus , в чашку СЛЕВА поместили диски ,пропитанные ГРУДНЫМ МОЛОКОМ, в чашку СПРАВА -диски со СМЕСЬЮ .
.
Что мы видим ? Четкие чистые круги вокруг дисков в чашке слева -это место ,где ГРУДНЫМ МОЛОКОМ БЫЛИ УНИЧТОЖЕНЫ БАКТЕРИИ , да и все остальное пространство чашки Петри гораздо более чистое ,чем слева. Справа же ,ГДЕ СМЕСЬ -не произошло никаких изменений , более того ,БАКТЕРИИ СТАЛИ ЕЩЕ АКТИВНЕЕ РАЗМНОЖ...
Мамочки, поделитесь! По поводу царапок на ручки. Моему почти 5 месяцев. И мы без них ни как не можем. Спим только в них. Раздирает детё себе лицо в области лба, переносицу, веки. Когда захотевает спать и во сне трет глазки и всё, кровавые полоски обеспечены. Ногти подстригаю под корень, хватает на день. Но не могу же я стричь каждый день. Да и больно пальчикам так, наверное. Бодрствуем без них. Может способствует аллергия на лице, зудит. Но почему то только во сне. Кто сталкивался с этой проблем...
Египет открыли?